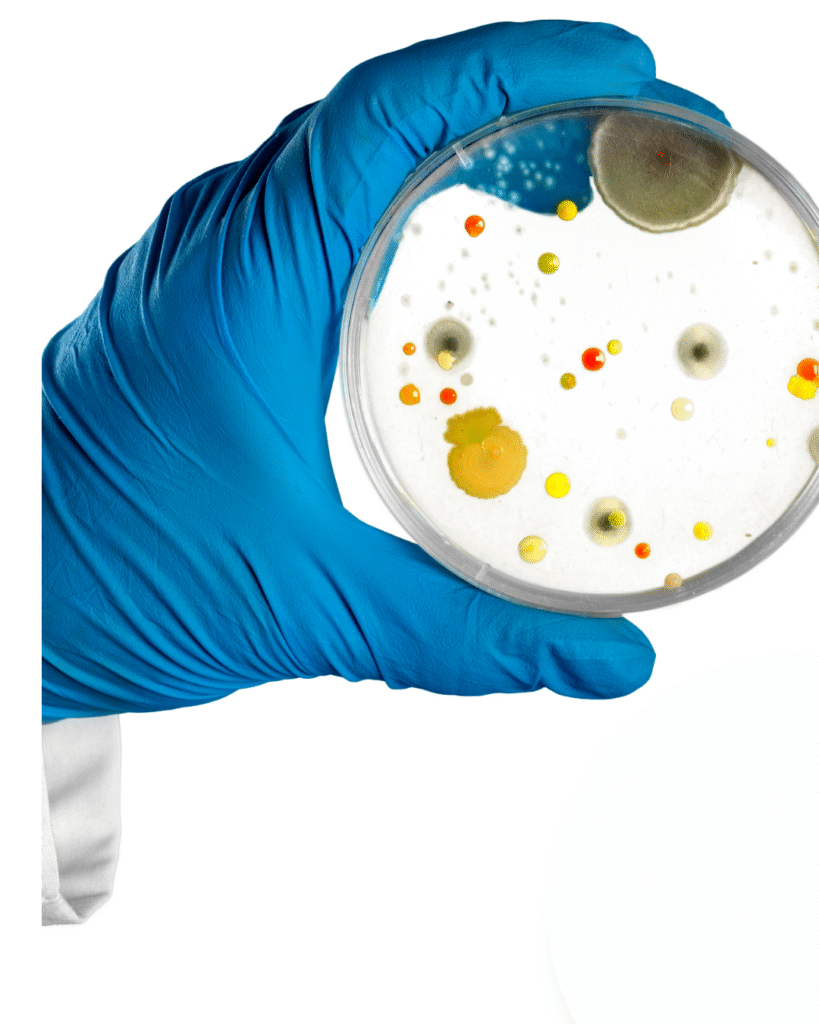

長野県立科町――その名を聞けば、多くの方がまず思い浮かべるのは「五輪久保のりんご」かもしれません。
五輪久保は、“サンふじ無袋栽培発祥の地”として知られ、名実ともに日本のりんご文化を牽引してきた地域です。
その確かなブランド価値は、いわばフランス・ボルドーにおける「五大シャトー」のような存在。
豊かな自然条件と磨き抜かれた技術が、名声を築いてきました。
しかし、フランスの銘醸地に名を馳せる“隣の畑”が、時に隠れた逸品を生み出すように――
アップルアートの畑がある「牛鹿(ushiroku)」も、五輪久保に寄り添いながら、
その同じ風と陽光、そして職人の手で、まったく遜色のない、むしろ新しい価値を生み出すりんごづく
りを続けています。

■ 五輪久保の隣、牛鹿という恵みの地
牛鹿は、五輪久保と同じ標高帯に位置し、
南に開けた緩やかな傾斜地に、朝から夕方までたっぷりと太陽の光が注ぎます。
浅間山の火山灰が生んだ黒ボク土は、水はけがよく、根の呼吸を助け、
昼夜の寒暖差が糖を蓄え、酸を引き締めます。
つまり、自然環境そのものは五輪久保と地続きであり、
アップルアートが丹精込めて育てるりんごは、同じ恵みを受けながら、
“牛鹿らしい香りと余韻”を湛えた、ひと味違う果実へと実を結ぶのです。
■ 伊勢神宮への奉納 ― 感謝と祈りを込めたりんご
アップルアートのりんごは、毎年伊勢神宮へ奉納されています。
これは単なる名誉ではなく、
「自然の恵みをいただき、人に喜びを届ける」その営みそのものへの感謝の証です。
神宮に奉納できるということは、
“清らかで安全である”ことの象徴でもあります。
農薬や化学肥料に極力頼らず、自然循環を重んじ、
一つひとつの実に、まるで祈りを込めるように手をかけています。

■ 牡蠣殻と微生物 ― 復興支援から生まれた土づくり
東日本大震災の直後、アップルアートは気仙沼へりんごジュースを支援物資として届けました。
そのご縁が、いまも形を変えて続いています。
気仙沼の牡蠣漁師さんたちからいただいた天然の牡蠣殻を、
私たちは粉砕して畑に還しています。
牡蠣殻にはカルシウムやマグネシウムなどのミネラルが豊富に含まれ、
それが土をやわらかくし、微生物のすみかをつくります。
さらにアップルア―トは、乳酸菌・酵母菌・ナットウ菌を独自に培養し、
この牡蠣殻とともに畑へ散布しています。
微生物たちは有機物を分解し、栄養をつくり、
病気に強い健康な根を育てます。
つまり、りんごの“おいしさ”は、
土の中の小さな命の力によって支えられているのです。

■ 微生物の調和がもたらす「旨み」と「余韻」
この自然循環的な栽培を続けることで、
りんごの糖度や香りだけでなく、味に深みと丸みが生まれます。
それは単なる「甘いりんご」ではなく、
酸味と香りの層が折り重なる“立体的な味わい”。
まるでワインやシードルのように、
その土地と微生物がつくる“テロワール”の個性が際立ちます。
■ シードルへ_発酵がつなぐ、土と人の物語
アップルアートのりんごは、そのまま食べてももちろん美味ですが、
もうひとつの楽しみ方として「シードル(りんご酒)」にも注目しています。
土の中で育まれた乳酸菌や酵母菌は、
果実の中にも微生物的な“個性”を宿します。
個性的なりんごを著名な醸造家が、
果実本来の香りを活かした、ナチュラルなシードルを作り出します。
アップルアートは今後、牛鹿のテロワールを活かした
小仕込みのクラフト・シードルづくりに挑戦しています。
それは、単なるお酒づくりではなく、
「自然と共生する農のあり方を味で伝える」試みです。
■ お客様に届けたい価値 ― “物語を食べる”という体験
お客様にとって、アップルアートのりんごは単なる果物ではなく、
「背景の見える安心」と「地域を感じる物語」を味わう体験です。
・伊勢神宮に奉納される清らかさ
・被災地との絆が生んだ循環の力
・微生物と自然が奏でる生命の調和
・五輪久保の名声に寄り添いながらも、独自の新風を吹き込む姿勢
それらすべてが、一口のりんごに込められています。
■ 五輪久保の隣、牛鹿から世界へ
五輪久保が日本の“Grand Cru(グラン・クリュ)”だとすれば、
私たち牛鹿はその**「プルミエ・クリュ(Premier Cru)」**。
同じ気候と地質に育まれながら、
より自由に、より創造的に自然の恵みを引き出しています。
現在、りんごだけでなく、ジュースやシードル、ドライアップルなどを通して、
“信州立科の自然循環型りんご文化”を県内外に発信しています。
終わりに
五輪久保に隣接する牛鹿――
そこには、同じ空気を吸いながらも、
より深く自然と共鳴するもう一つのりんごの物語があります。
牡蠣殻が海から山へ、微生物が土から実へ、
そして果実が人から人へと、命のバトンをつなぐ。
その循環の中に生まれる一粒のりんごを、
どうぞ味わってみてください。
きっとその甘みの奥に、「自然」「祈り」「再生」の香りを感じていただけるはずです。


